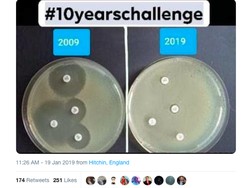
10 Years Challenge yang Ini Bikin Takut Minum Antibiotik

detikTravel
Kota Perth, Tempat Liburan Paling Semarak di Australia Barat
Kota Perth di Australia Barat adalah destinasi yang begitu seru dan semarak. Dari pagi sampai malam, banyak keceriaan yang bisa dinikmati para wisatawan.
Sabtu, 06 Apr 2019 17:24 WIB